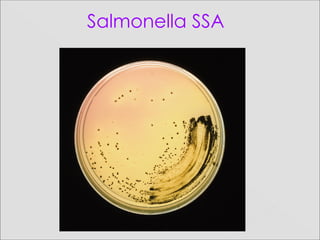
Salmonella SSA
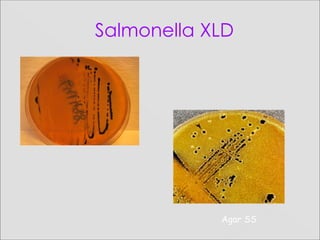
Salmonella XLD
Agar SS
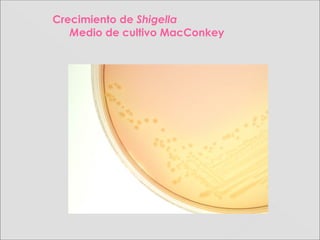
Crecimiento de Shigella
Medio de cultivo MacConkey
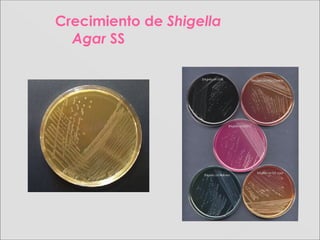
Crecimiento de Shigella
Agar SS

Este documento describe el género Salmonella, un bacilo gramnegativo que causa salmonelosis. Pertenece a la familia Enterobacteriaceae y puede causar fiebre tifoidea, infecciones sistémicas y diarrea. Se transmite por alimentos o agua contaminados y sus síntomas incluyen fiebre, náuseas y diarrea. El tratamiento incluye antibióticos como ciprofloxacina. La prevención requiere higiene alimentaria y personal adecuadas.












![SalmonellaSalmonella
Colonización asintomática
(principalmente con S. typhi y S.
paratyphi)
Fiebre entérica (llamada también fiebre
tifoidea [S. typhi] o fiebre paratifoidea [S.
paratyphi])
Enteritis caracterizada por fiebre,
náuseas, vómitos, diarrea sanguinolenta
o no sanguinolenta y espasmos
abdominales.
Bacteriemia (frecuente en S. typhi, S.
CUADROCUADRO CLÍNICOCLÍNICO](https://image.slidesharecdn.com/108-161021191422/85/108-pw-sal-shi_2016_uc-13-320.jpg)